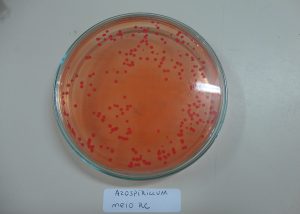

Brasil tem o 1º laboratório público de pesquisa acreditado para análise de inoculantes e identificação de microrganismos
O Laboratório de Biotecnologia do Solo da Embrapa Soja (PR) recebeu, em março de 2021, a acreditação do Instituto Nacional de Metrologia, Qualidade e Tecnologia (Inmetro) na norma ISO 17025:2017, tornando-se o primeiro laboratório de pesquisa público brasileiro apto a realizar análises de inoculantes e identificação de microrganismos.
A certificação de um laboratório para ISO 17025 não é simples, afinal trata-se de uma instituição que precisa de resultados precisos e fiéis aos experimentos. Para conseguir um certificado ISO 17025, o laboratório precisa se preocupar com todos os processos dos testes e/ou calibragem, desde a gestão e definições até o os processos técnicos. São aspectos importantes para a certificação:
- Referências normativas
- Definições e termos
- Requisitos de gestão
- Requisitos técnicos
O reconhecimento do Inmetro impacta positivamente o mercado de insumos biológicos, em franco crescimento no País, com a comercialização de mais de 70 milhões de doses de inoculantes na última safra. Abre também portas para a exportação de bioinsumos pela indústria nacional.
Nesta certificação do Inmetro, foram acreditados quatro ensaios biológicos, incluindo a avaliação da concentração e de pureza de inoculantes líquidos e turfosos, de recuperação de células inoculadas nas sementes e de identidade de microrganismos inoculantes.
Com esse reconhecimento, a Embrapa Soja passa a compor o seleto grupo de laboratórios internacionais com acreditação para garantir a produção de bioinsumos.
De acordo com o analista de dados e pesquisador do Grupo Esperança Rural, prof. Otávio Luz, “o papel da Embrapa através de vários pesquisadores no desenvolvimento das tecnológicas para uso e qualificação do controle biológico, é internacionalmente reconhecida e exemplo para vários países. A norma técnica internacional ISO 17025:2017 do Inmetro, traduz a importância e renome do Laboratório de Biotecnologia do Solo da Embrapa Soja (PR), e seus renomados pesquisadores”.
O Laboratório é também a única estação quarentenária de inoculantes homologada pelo MAPA, um segmento com demanda crescente de serviços por indústrias brasileiras e internacionais. Em seu acervo consta-se uma coleção de 4.500 estirpes armazenadas representando um enorme potencial biotecnológico
Fonte:
Por Lebna Landgraf (MTB 2903 /PR) – Disponível em :